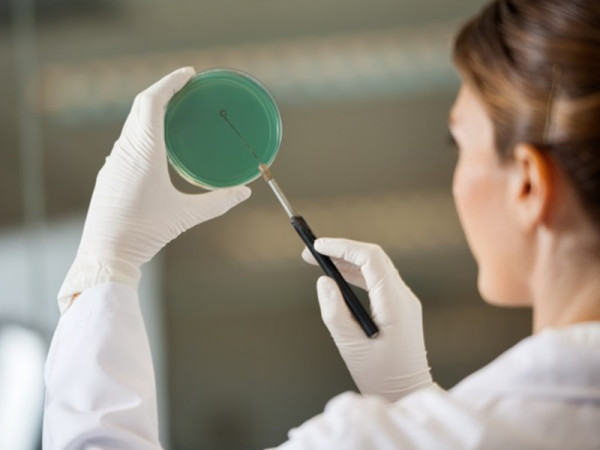
Reason-10

20 LÝ DO ĐỂ PHÁI ĐẸP LỰA CHỌN PEVONIA LÀ SẢN PHẨM CHĂM SÓC SẮC ĐẸP
Pevonia là một thương hiệu chăm sóc da chuyên nghiệp hàng đầu tại Mỹ, đã rất thành công trong việc kết hợp chính xác giữa công nghệ tiên tiến nhất và những thành phần hoạt tính tinh khiết của tự nhiên, tất cả cho ra những sản phẩm công hiệu tuyệt vời tuyệt đối không có phản ứng phụ. Hãy cùng điểm qua những lý do vì sao phái đẹp lựa chọn Pevonia là sản phẩm chăm sóc sắc đẹp nhé…
- Thành phần tự nhiên. Hiệu quả chuyên nghiệp.
2.Không Paraben
3. Không có màu sắc nhân tạo

4. Không Sodium Lauryl Sulfate
5. Không có Formaldehyde
6. Không cồn
7. Không Lanolin
8. Không dầu khoáng

10. Không Urea
11.Chiết xuất hữu cơ
12.Tinh dầu hữu cơ
13. Hoạt chất mới nhất đã được chứng minh hiệu quả
14.Nâng cao công nghệ sản xuất xanh
15.Nâng tầm hiệu quả trong trị liệu tại spa
16. Phác đồ sử dụng tại nhà hiệu quả
17. Gặt hái thủ công
18. Cam kết An toàn Mỹ phẩm
19. Công thức không thử nghiệm trên động vật
20. Đóng gói sinh thái
Chào mừng bạn ghé thăm website!
Đăng ký để nhận các bài viết mới nhất của chúng tôi qua email!